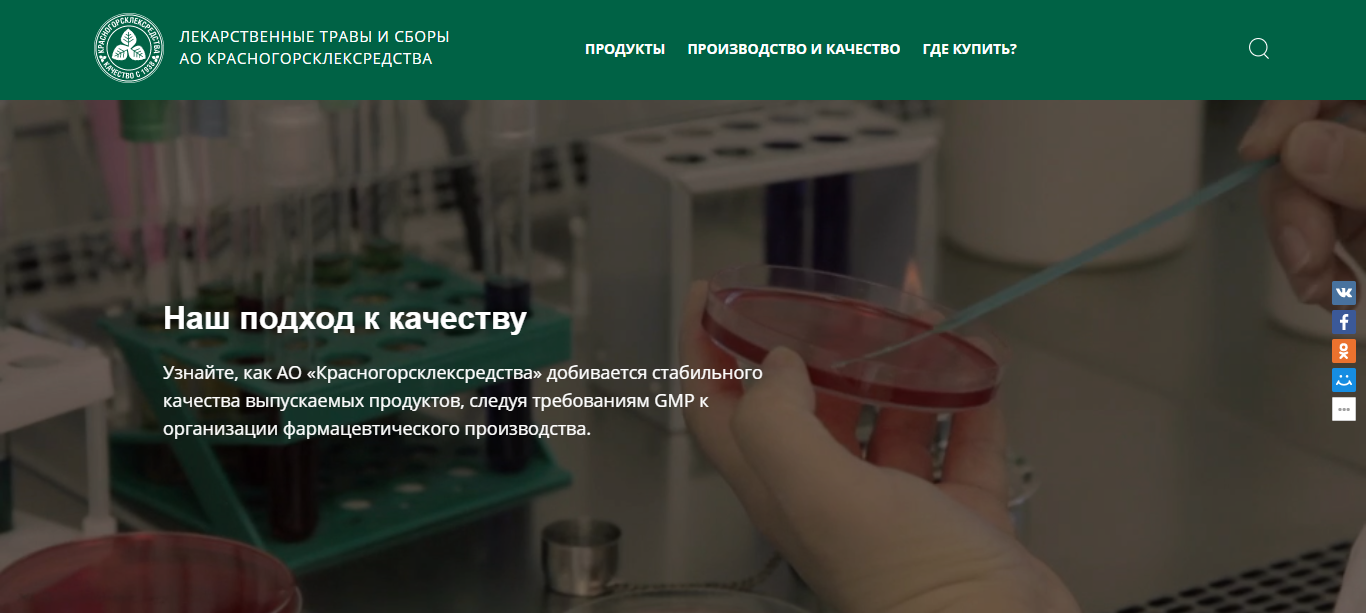
Красногорсклексредства-3

Клиент: АО «Красногорсклексредства»
Тип проекта: интернет-витрина.
О проекте
Сотрудники компании АО «Красногорсклексредства» обратились в Cetera с целью получить предложение по развитию и поддержке сайта krls.ru. Cetera предложили реализацию проекта по моделе «Безлимитное абонентское обслуживание». Подробнее о методологии на сайте — https://cetera.ru/about/custom-development/complexservice/.
Платформа
В основе проекта — система управления контентом «1С-Битрикс».
Разработка
Проект был принят на обслуживание в апреле 2013 года.
После переноса сайта на новый выделенный сервер мы приступили к редизайну и полностью оптимизировали код сайта.
Верстка выполнена на framework Foundation 6.0. Обеспечена адаптивная вёрстка. Код прошёл тестирование на соответствие стандартам W3C.
Программирование выполнялось на PHP.
Контроль качества проводился автоматическими системами. Обеспечено соответствие стандартам PSR для PHP. Пройдены все встроенные тесты (безопасность, производительность, неизменность ядра и т.д.) системы управления контентом.
Впоследствии мы наращивали и оптимизиовали функционал на сайте, а также сайт претерпел редизайн в нескольких итерациях.
Дизайн

Дальнейшее развитие
Cetera продолжает поддерживать и развивать проект по модели «Безлимитное абонентское обслуживание» по заявкам заказчика и по рекомендациям специалистов Cetera.
Июль 2021
- Техподдержка.
- Хостинг, администрирование.
Август 2021
- Отработать рекомендации по оптимизации сайта https://www.krls.ru/ по итогам тестирования.
- Техподдержка.
- Хостинг, администрирование.
Сентябрь 2021
- Мероприятия по итогам аудита страниц с наибольшими отказами.
- Техподдержка.
- Хостинг, администрирование.
Октябрь 2021
- Обновить Битрикс.
- Базовый СЕО-аудит сайта.
- Аудит коммерческих факторов сайта.
Ноябрь 2021
- Мероприятия по итогам базового СЕО-аудит сайта.
- Настройка нового сервера, перенос сайтов на этот сервер (первый этап).
Декабрь 2021
- Настройка нового сервера, перенос сайтов на этот сервер (второй этап).
- Развернуть сайт https://immunofitol.ru/.
- Развернуть сайт https://verdiogast.ru/.
Январь 2022
- Изменения в каталог продуктов.
Февраль 2022
- Развернуть сайт Бронхофитол на сервере.
- Техподдержка.
- Хостинг, администрирование.
Март–апрель 2022
- Техподдержка.
- Хостинг, администрирование.
Май 2022
- Верстка макетов промосайта фиточай «Щедрость природы».
- Техподдержка.
- Хостинг, администрирование.
Июнь 2022
- Стилизовать самое верхнее (малое меню).
- Техподдержка.
- Хостинг, администрирование.
Июль 2022
- Обновить 1С Битрикс.
- Техподдержка.
- Хостинг, администрирование.
Август 2022
- Техподдержка.
- Хостинг, администрирование.
Сентябрь 2022
- Доработки по сайту фиточая «Щедрость природы».
- Техподдержка.
- Хостинг, администрирование.
Октябрь–ноябрь 2022
- Техподдержка.
- Хостинг, администрирование.
Декабрь 2022
- Базовый СЕО-аудит сайта.
- Техподдержка.
- Хостинг, администрирование.
Январь 2023
- Мероприятия по итогам базовый СЕО-аудита сайта https://www.krls.ru/ (первый этап).
- Техподдержка.
- Хостинг, администрирование.
Февраль 2023
- Мероприятия по итогам базового СЕО-аудита сайта https://www.krls.ru/ (продолжение работ).
- Техподдержка.
- Хостинг, администрирование.
Март 2023
- Проработать адаптивную верстку на мобильных устройствах.
- Оптимизация быстродействия сайта.
- Техподдержка.
- Хостинг, администрирование.
Апрель 2023
- Внедрить доработанную адаптивную верстку на сайт.
- Мероприятия по итогам базового СЕО-аудита сайта (остатки):
- Исправление ошибок в Яндекс.Вебмастер и Google Search Console.
- Подключение турбо страниц.
- Разметка Schema.org для картинок.
- Техподдержка.
- Хостинг, администрирование.
Май 2023–январь 2025
- Техподдержка.
- Хостинг, администрирование.
Февраль 2025
- Обновление CMS Bitrix до актуальной версии.
- Переход сайта на PHP 8.4.
- Техподдержка.
- Хостинг, администрирование.
Март 2025–март 2026
- Техподдержка.
- Хостинг, администрирование.
Похожие кейсы
Сайт с каталогом для компании «Пожарная Автоматика»
Сайт с каталогом для «ДизельЭнергоРесурс»
Сайт с каталогом для «Газпромнефть — Битумные материалы»
Сайт с каталогом для компании «ОриенталБридж»
Сайт с каталогом для завода «БАЗАЛЬТЕК»
Сайт с каталогом для «Пакленд Защитная Упаковка»